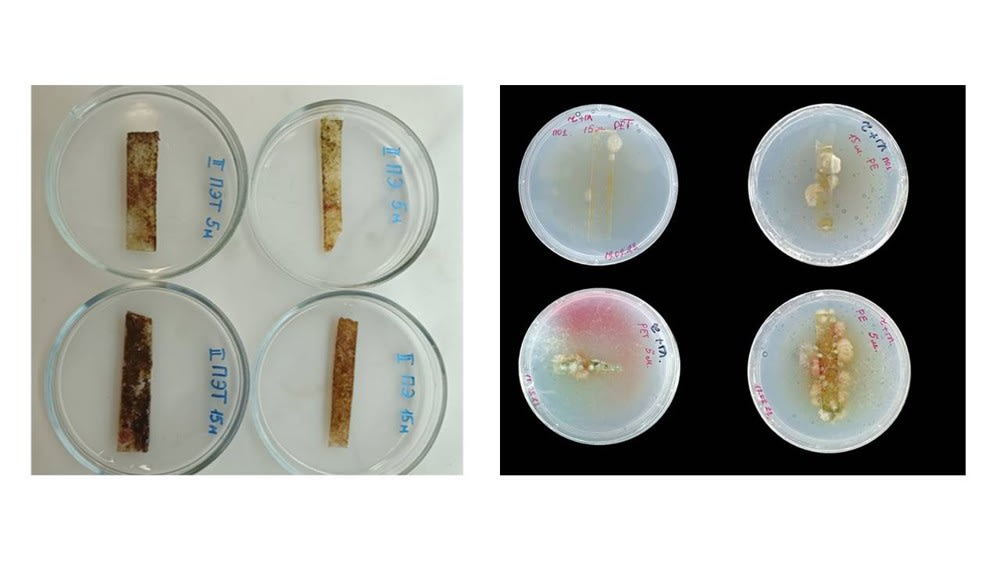

В поисках особенных грибов
Иркутские ученые ищут в Байкале организмы, которые способны переработать пластик
В 2024 году академическая наука Восточной Сибири отмечает 75-летие. В честь этого события редакция газеты «Областная» при содействии Иркутского филиала Сибирского отделения РАН публикует цикл материалов о молодых ученых Приангарья.
Байкальский музей СО РАН проводит уникальный эксперимент. Исследователи изучают микроорганизмы, которые под водой обрастают на разных видах пластика. В первую очередь специалисты обращают внимание на пока малоизученные микроскопические байкальские грибы и надеются найти среди них потенциальных деструкторов пластиковых отходов. В эксперименте участвуют и молодые ученые. Сегодня мы расскажем о работе аспиранта Байкальского музея, младшего научного сотрудника лаборатории физиологической генетики СИФИБР СО РАН Марины Поляковой.
Невидимый мир байкальской пластисферы
– Ну посмотрите – какая красота! Вот сердечко, облако, цветок. А здесь вообще Винни-Пух какой-то, – до встречи с Мариной Поляковой я думала, что только Анну Ахматову помимо одуванчиков у забора могла вдохновлять и «таинственная плесень на стене». Аспирант Байкальского музея показывает мне снимки этой самой плесени и других микроскопических грибов, готовясь к мини-выставке. Девушка искренне восхищается объектами своего научного интереса. Посетители музейных экспозиций тоже смогут оценить фотографии этих созданий.
Выставка называется «Невидимый мир пластисферы озера Байкал». Пластисфера – звучит красиво. Но речь идет об отходах пластика, вернее, о разнообразных сообществах микроорганизмов, которые образуются на них. 17 июня ученые Байкальского музея СО РАН как раз поднимали со дна представителей этих сообществ. В погружении участвовал директор музея, кандидат биологических наук Александр Купчинский..

– Наше учреждение несколько отличается от других академических институтов региона. У нас две миссии: научно-исследовательская и научно-просветительская. Считаю, что мы находимся на вершине пирамиды, основанием которой являются все институты, а мы представляем их наработки, открытия, исследования для широкой публики. Но и наше собственное научное направление достаточно сильно сейчас развивается, – рассказал директор Байкальского музея.
Ровно год назад ученые установили на дне Байкала в Листвянке две металлические планки с «лепестками» из разных видов пластика – ПЭТ, полиэтиленом, холлофайбером. Последний материал используется в изготовлении одежды, и считается, что после ее стирки в окружающую среду попадает много микропластика. А для науки это злободневная тема.

– Пластика, микропластика все больше во всем мире. В Байкале он тоже накапливается. А что с ним будет дальше, какое влияние он оказывает на живые организмы и как передается по пищевым цепочкам – неизвестно. Мы пока смотрим, какими микроорганизмами обрастает тот или иной вид пластика. Изучение темы будем развивать и дальше, – продолжил Александр Купчинский.

Вместе с коллегой он облачился в водолазный костюм и, проверив снаряжение, погрузился на дно Байкала. Планки обрастания – ловушки – ученые разместили на глубине 5 и 15 метров. Глядя в прозрачную изумрудную воду с борта научно-исследовательского судна «Профессор А.А. Тресков», кажется, что это совсем близко, и дело кончится быстро. Но участникам эксперимента нельзя спешить. Сначала с планок нужно аккуратно срезать и убрать в пробирки биологический материал.
Байкал – попадание в самое сердце
Пока водолазы работают в глубине, с другими учеными остаемся на судне. Для Марины Поляковой корабельная жизнь не в новинку. Она участвовала в байкальских экспедициях вместе с лимнологами. Да и ее отец – сам капитан корабля. Девушка выросла в якутском поселке речников Жатай. После окончания школы с серебряной медалью поехала не на запад страны, как большинство одноклассников, а в Сибирь.

– Когда я, будучи студенткой естественно-географического факультета Иркутского педуниверситета, приехала на практику в Большое Голоустное и увидела Байкал, это было попадание в самое сердце. Кто-то спорит, какой берег – восточный или западный – лучше, а я этого не понимаю. Они разные, но оба совершенно прекрасные, – уверена Марина Полякова.
Микроскопические грибы, которыми искренне восхищается молодой ученый сейчас, далеко не сразу стали главным объектом изучения. Еще в школе она с интересом смотрела передачи о спасении животных и мечтала участвовать в таких экологических миссиях. В вузе потом изучала орнитологию, птиц-дуплогнездников. Попутно студенткой решила пойти на подработку в Сибирский институт физиологии и биохимии растений СО РАН:
– Я просто поняла, что подрабатывать официантом – не мое дело. Узнала, что в этом институте есть оранжерея, и решила, что лучше буду возиться с растениями. Мы высаживали в городе клумбы, в том числе и сюда приезжали, в Листвянку, к Байкальскому музею. Из всех точек посадок цветов здесь была наша самая любимая, потому что люди приветливые, когда они видели, что мы сажаем цветы, подходили, благодарили – какая красота. После окончания университета с красным дипломом планировала работать в лицее. Но в тот момент оранжереей в СИФИБРе руководила Татьяна Пензина, она мне посоветовала остаться в институте. И я сделала выбор в его пользу. А потом Татьяна Александровна сказала, что мои руки – для работы в лаборатории.
Так в научной жизни Марины стала появляться грибная тема. Для обычных людей она, как правило, зиждется лишь на том, какой гриб съедобен, а какой ядовит. У ученых, которые занимаются байкальскими представителями этого царства живой природы, вопросов гораздо больше. Тема, оказывается, мало изучена.
Грибы как знак антропогенного воздействия на природу
– Чем больше мы хотим что-то узнать о грибах Байкала, об обитателях пластисферы, тем больше вопросов, – констатирует заместитель директора по научной работе Байкальского музея, кандидат биологических наук Елена Минчева. – Пока очень много организмов невозможно идентифицировать по международной базе данных нуклеотидных последовательностей. Образцы, полученные в чистых культурах, на филогенетических деревьях образуют отдельные клады. Скорее всего, нас ждет много новых открытий. Какие-то виды просто еще не описаны. Проконсультироваться по морфологии грибов практически не с кем. Специалистов по микроскопическим грибам в России немного. Мы становимся своего рода первооткрывателями байкальских грибов.
С Еленой Минчевой и ее коллегой из Лимнологического института СО РАН, заведующим лабораторией геносистематики Дмитрием Щербаковым Марина Полякова познакомилась, когда они пришли в СИФИБР и попросили сделать посев – смотрели, как грибы ассоциированы с байкальскими зелеными водорослями. Несмотря на то что совместные работы иркутских ученых по изучению микроскопических грибов (микромицетов) начались не так давно, первые результаты уже есть.

– Мы проводили эксперимент с заместителем директора по науке Лимнологического института, заведующим лабораторией биомолекулярных систем Вадимом Владимировичем Анненковым. Его лаборатория синтезировала наночастицы пластика, которые светятся. Этим пластиком мы кормили гриб питиум. После этого гриб весь засветился, а через четыре часа перестал. Таким образом питиум что-то сделал с пластиком. Еще мы обратили внимание на грибы – паразиты беспозвоночных животных – зоопагомицеты. Мы исследовали много образцов в разных районах Байкала и обнаружили их только в районе БЦБК. А сейчас они поселились в Листвянке. Мы предполагаем, что зоопагомицеты могут быть маркером антропогенной нагрузки, – считает Елена Минчева.

Тем временем водолазы завершают свою работу, поднимают на борт пробы и обросшие чем-то слизким и пахучим рамки с разными видами пластика и с пластиковыми же бутылками, которые служили поплавками. С забранной у места эксперимента водой попались три больших гаммаруса. Рачков после карантина поместят в аквариумную экспозицию музея, а зеленый нарост рамок сразу же отправляется на исследования.
То, что музей находится рядом с местом погружения, – большой плюс для чистоты эксперимента. А в этом году в учреждении планируется открыть еще и лабораторию молекулярно-генетических исследований.
В ожидании деструкторов пластика
Марина Полякова берет небольшое количество оброста, опускает его в стерильную воду, взбалтывает для получения суспензии. Тщательно ее растирает, чтобы потом изолировать отдельные колонии грибов. Их поместят в емкость, где кроме минеральных солей для микромицетов будет только один источник углерода – пластиковый порошок. Выращивают колонию ученые при температуре +10 градусов, примерно, как в Байкале. Через месяц посмотрят, выживут ли грибы, если да, значит, питались они исключительно пластиком.
– Раньше мое отношение к микроскопическим грибам было скорее пренебрежительным. Но когда я начала заниматься их культивированием, то эти грибы открылись как совершенно удивительные организмы. Их значение и пользу сложно переоценить. Достаточно вспомнить тот же пенициллин. Из грибов получают множество ферментов. На их основе делают лекарства. Благодаря богатому ферментному аппарату грибы в природе являются основными деструкторами органики и ксенобиотиков. Если бы не было грибов, органика бы непрерывно накапливалась, исключая элементы из круговорота. Нужно смотреть правде в глаза – человечество пока не готово отказаться от пластика. Поэтому мы надеемся, что найдем виды грибов-деструкторов в Байкале. Возможно, будут разработаны новые технологии переработки пластика, не вредящие человеку и окружающей среде. Ведь в конечном итоге грибы способны разлагать полимеры до углекислого газа и воды, – говорит Марина.

Помимо работы в двух институтах, учебы в аспирантуре, девушка участвует во всероссийских научных и экологических проектах. В «Байкальской экспедиции» она встретила единомышленников, с которыми участвовала в умных субботниках на Байкале. Была в экспедициях на Баренцевом море. В очередную поездку туда молодой иркутский ученый отправляется как раз в день открытия выставки в Байкальском музее. Марина Полякова недавно прошла отбор по программе «Арктический плавучий университет». Ее ждет месяц жизни на корабле; суровая, давно полюбившаяся северная природа и все те же микроскопические создания, на которых она с коллегами возлагает большие научные надежды.

Деструкторы – это организмы (в основном бактерии и грибы), которые разрушают отмершие останки живых существ, превращая их в неорганические и простейшие органические соединения.



